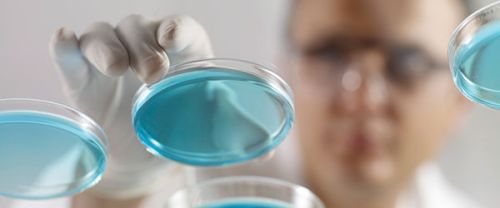
Life Science

- Supply TypeManufacturer, Exporter, Supplier
- Preferred Buyer Location All over the world
After the completion of the human genome project, life science research entered a new era of scientific advancement. While biology remains the centerpiece of the life sciences, technological advances have sparked a rapid growth of specializations and interdisciplinary fields including bioinformatics, genomics and proteomics.